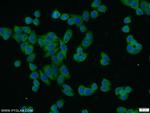
IKBKG Antibody in Immunocytochemistry (ICC/IF)

Search
Proteintech
IKBKG Polyclonal Antibody
{{$productOrderCtrl.translations['antibody.pdp.commerceCard.promotion.promotions']}}
{{$productOrderCtrl.translations['antibody.pdp.commerceCard.promotion.viewpromo']}}
{{$productOrderCtrl.translations['antibody.pdp.commerceCard.promotion.promocode']}}: {{promo.promoCode}} {{promo.promoTitle}} {{promo.promoDescription}}. {{$productOrderCtrl.translations['antibody.pdp.commerceCard.promotion.learnmore']}}
产品信息
18474-1-AP
种属反应
已发表种属
宿主/亚型
分类
类型
抗原
偶联物
形式
浓度
规格
纯化类型
保存液
内含物
保存条件
运输条件
产品详细信息
Immunogen sequence: QALREVEHL KRCQQQMAED KASVKAQVTS LLGELQESQS RLEAATKECQ ALEGRARAAS EQARQLESER EALQQQHSVQ VDQLRMQGQS VEAALRMERQ AASEEKRKLA QLQVAYHQLF QEYDNHIKSS VVGSERKRGM QLEDLKQQLQ QAEEALVAKQ EVIDKLKEEA EQHKIVMETV PVLKAQADIY KADFQAERQA REKLAEKKEL LQEQLEQLQR EYSKLKASCQ ESARIEDMRK RHVEVSQAPL PPAPAYLSSP LALPSQRRSP PEEPPDFCCP KCQYQAPDMD TLQIHVMECI E (120-419 aa encoded by BC012114)
靶标信息
IKK gamma is the regulatory subunit of the inhibitor of the kappaB kinase (IKK) complex, which activates NF-kappaB resulting in activation of genes involved in inflammation, immunity, cell survival, and other pathways. Mutations in this gene result in incontinentia pigmenti, hypohidrotic ectodermal dysplasia, and several other types of immunodeficiencies. Multiple transcript variants encoding different isoforms have been found for this gene. A pseudogene highly similar to this locus is located in an adjacent region of the X chromosome.
仅用于科研。不用于诊断过程。未经明确授权不得转售。
生物信息学
蛋白别名: 14.7K (adenovirus E3 protein) interacting protein 3; FIP-3; gikk; I-kappa-B kinase gamma; I-kappa-B kinase subunit gamma; ikB kinase subunit gamma; IkB kinase-associated protein 1; IKK-gamma; IKK3; IKKAP1; IKKG; incontinentia pigmenti; inhibitor of kappa light polypeptide gene enhancer in B-cells, kinase gamma; inhibitor of kappaB kinase gamma; inhibitor of nuclear factor kappa B kinase subunit gamma; Inhibitor of nuclear factor kappa-B kinase subunit gamma; mF; mFIP-3; NEMO; NF-kappa B essential modulator; NF-kappa-B essential modifier; NF-kappa-B essential modulator; NF-kB essential modulator; OTTHUMP00000207079; OTTHUMP00000212188
基因别名: 1110037D23Rik; AI848108; AI851264; AMCBX1; AW124339; EDAID1; FIP-3; FIP3; Fip3p; IKBKG; IKK-gamma; IKK[g]; IKKAP1; IKKG; IMD33; IP; IP1; IP2; IPD2; NEMO; SAIDX; ZC2HC9
UniProt ID: (Human) Q9Y6K9, (Mouse) O88522, (Rat) Q6TMG5
Entrez Gene ID: (Human) 8517, (Mouse) 16151, (Rat) 309295